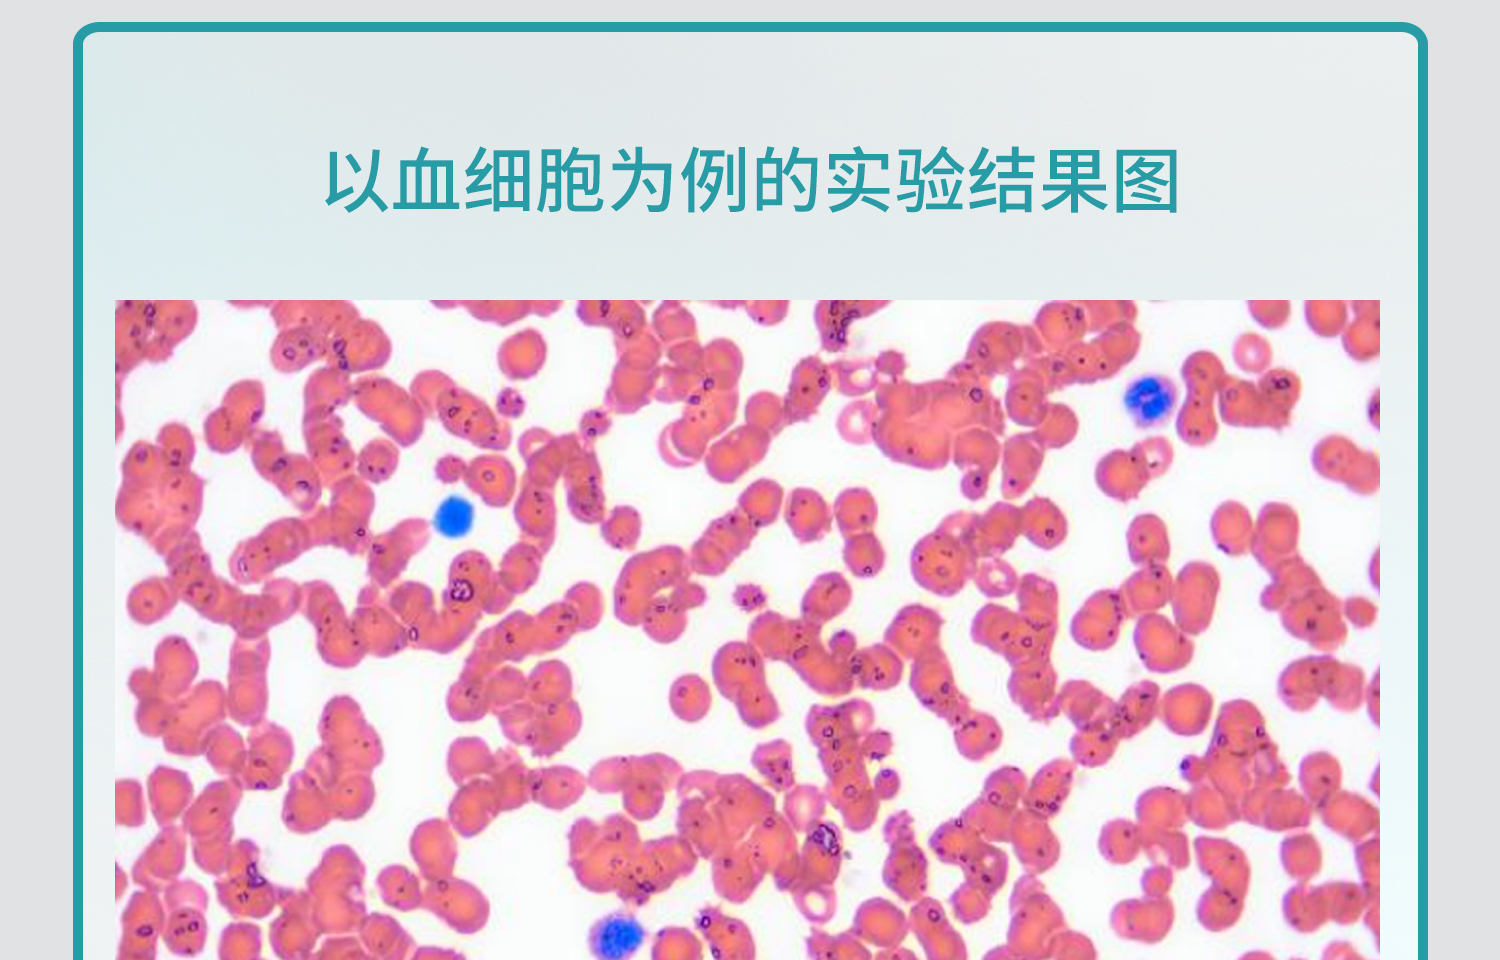
BKM-迪夫快速染色液_13.jpg

中文版
English
加入收藏
迪夫染色液
产品名称:迪夫染色液
产品品牌:BKMAMLAB
产品规格:
-
迪夫染色液3*100mL 110703048
-
迪夫染色液3*250mL 110703049
-
迪夫染色液3*500mL 110703050
-
迪夫染色液I液1*100mL 110703051
-
迪夫染色液I液1*250mL 110703052
-
迪夫染色液I液1*500mL 110703053
-
迪夫染色液II液1*100mL 110703054
-
迪夫染色液II液1*250mL 110703055
-
迪夫染色液II液1*500mL 110703056
-
迪夫染色液固定液1*100mL 110703057
-
迪夫染色液固定液1*250mL 110703058
-
迪夫染色液固定液1*500mL 110703059